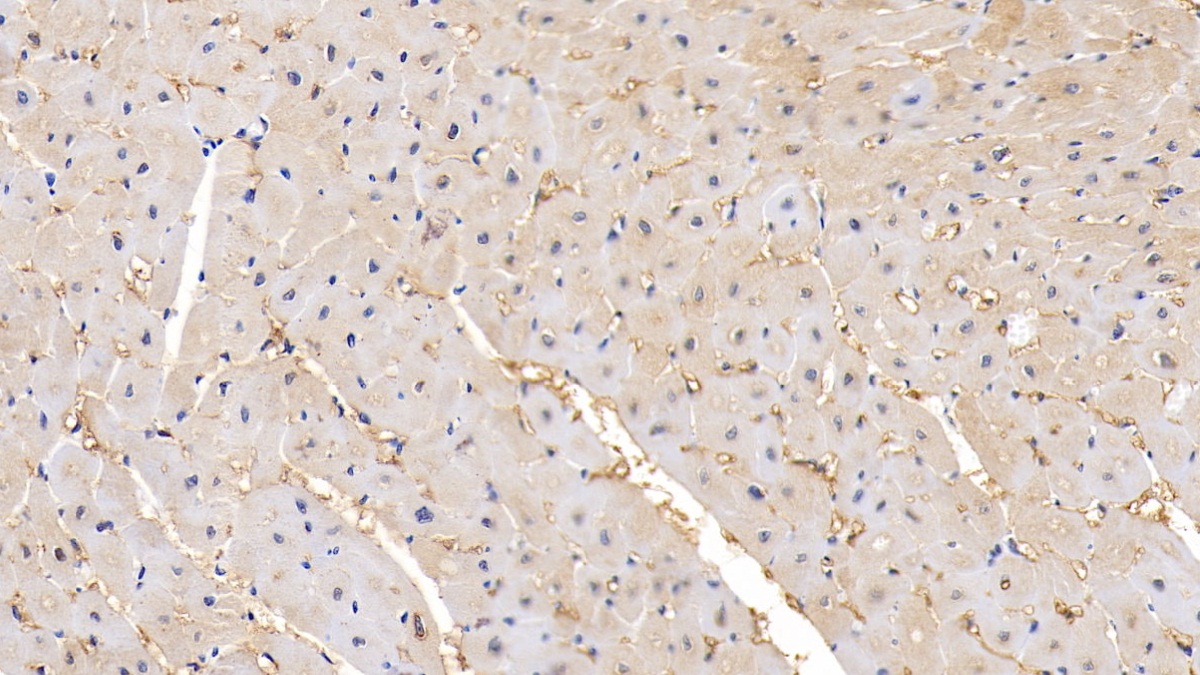
https://d1vffmuvmgkypt.cloudfront.net/image/ridacom_ltd/cloud_clone_corp/PRODUCT_SOURCE__CLOUD_CLONE__SUPPLIER__RIDACOM__ID__PAA100Hu02__3

Antigen
CLG4
Reactivity
Human
(10)
Mouse
(3)
Rat
(3)
Rabbit
(2)
Pig
(1)
Wild boar
(1)
Research area
Enzyme & Kinase
(11)
Infection immunity
(11)
Tumor immunity
(11)
Clonality
Polyclonal
(3)
Monoclonal
(1)
Application
Western Blotting
(10)
Immunocytochemistry
(6)
Immunohistochemistry
(6)
Chemiluminescent immunoassay for antigen detection
(4)
Enzyme-linked immunosorbent assay for Antigen Detection
(4)
Immunoprecipitation
(4)
Positive Control
(4)
SDS-PAGE
(4)
Cell Culture
(1)
Immunofluorescence
(1)
Host
Rabbit
(3)
293F
(1)
CHO
(1)
Mouse
(1)
Category
ELISA Kits
(8)
Antibodies
(6)
Cell biology
(5)
Immunochemicals
(5)
Protein Biochemistry
(5)
| 48T | $638.00 | |
| 96T | $912.00 | |
| 96T*5 | $4,104.00 |
| 96T*10 | $7,752.00 | |
| 96T*100 | $63,840.00 |
| 48T | $638.00 | |
| 96T | $912.00 | |
| 96T*5 | $4,104.00 |
| 96T*10 | $7,752.00 | |
| 96T*100 | $63,840.00 |
| 48T | $605.00 | |
| 96T | $864.00 | |
| 96T*5 | $3,888.00 |
| 96T*10 | $7,344.00 | |
| 96T*100 | $60,480.00 |
| 48T | $588.00 | |
| 96T | $840.00 | |
| 96T*5 | $3,780.00 |
| 96T*10 | $7,140.00 | |
| 96T*100 | $58,800.00 |

Antigen:
Matrix Metalloproteinase 2
Synonyms: CLG4; CLG4A; MMP-II; MONA; TBE-1; PEX; Gelatinase A; 72kDa Gelatinase; 72kDa Type IV Collagenase
Reactivity:Human
Application:Cell Culture
Research area:Enzyme & Kinase; Tumor immunity; Infection immunity
Preparation method:Escherichia coli
| 10µg | $292.00 | |
| 50µg | $730.00 | |
| 200µg | $1,460.00 |
| 1mg | $4,380.00 | |
| 5mg | $10,950.00 |
| 48T | $479.00 | |
| 96T | $684.00 | |
| 96T*5 | $3,078.00 |
| 96T*10 | $5,814.00 | |
| 96T*100 | $47,880.00 |
| 48T | $479.00 | |
| 96T | $684.00 | |
| 96T*5 | $3,078.00 |
| 96T*10 | $5,814.00 | |
| 96T*100 | $47,880.00 |
| 48T | $454.00 | |
| 96T | $648.00 | |
| 96T*5 | $2,916.00 |
| 96T*10 | $5,508.00 | |
| 96T*100 | $45,360.00 |

Antigen:
Matrix Metalloproteinase 2
Synonyms: CLG4; CLG4A; MMP-II; MONA; TBE-1; PEX; Gelatinase A; 72kDa Gelatinase; 72kDa Type IV Collagenase
Reactivity:Mouse
Application:Positive Control; SDS-PAGE; Western Blotting
Research area:Enzyme & Kinase; Tumor immunity; Infection immunity
Preparation method:Escherichia coli
| 10µg | $216.00 | |
| 50µg | $540.00 | |
| 200µg | $1,080.00 |
| 1mg | $3,240.00 | |
| 5mg | $8,100.00 |

Antigen:
Matrix Metalloproteinase 2
Synonyms: CLG4; CLG4A; MMP-II; MONA; TBE-1; PEX; Gelatinase A; 72kDa Gelatinase; 72kDa Type IV Collagenase
Reactivity:Human
Application:Positive Control; SDS-PAGE; Western Blotting
Research area:Enzyme & Kinase; Tumor immunity; Infection immunity
Preparation method:Escherichia coli
| 10µg | $208.00 | |
| 50µg | $520.00 | |
| 200µg | $1,040.00 |
| 1mg | $3,120.00 | |
| 5mg | $7,800.00 |

Antigen:
Matrix Metalloproteinase 2
Synonyms: CLG4; CLG4A; MMP-II; MONA; TBE-1; PEX; Gelatinase A; 72kDa Gelatinase; 72kDa Type IV Collagenase
Reactivity:Human
Application:Positive Control; SDS-PAGE; Western Blotting
Research area:Enzyme & Kinase; Tumor immunity; Infection immunity
Preparation method:Escherichia coli
| 10µg | $208.00 | |
| 50µg | $520.00 | |
| 200µg | $1,040.00 |
| 1mg | $3,120.00 | |
| 5mg | $7,800.00 |

Antigen:
Matrix Metalloproteinase 2
Synonyms: CLG4; CLG4A; MMP-II; MONA; TBE-1; PEX; Gelatinase A; 72kDa Gelatinase; 72kDa Type IV Collagenase
Reactivity:Rat
Application:Positive Control; SDS-PAGE; Western Blotting
Research area:Enzyme & Kinase; Tumor immunity; Infection immunity
Preparation method:Escherichia coli
| 10µg | $188.00 | |
| 50µg | $470.00 | |
| 200µg | $940.00 |
| 1mg | $2,820.00 | |
| 5mg | $7,050.00 |
| 48T | $293.00 | |
| 96T | $419.00 | |
| 96T*5 | $1,886.00 |
| 96T*10 | $3,562.00 | |
| 96T*100 | $29,330.00 |

Antigen:
Matrix Metalloproteinase 2
Synonyms: CLG4; CLG4A; MMP-II; MONA; TBE-1; PEX; Gelatinase A; 72kDa Gelatinase; 72kDa Type IV Collagenase
Host:Rabbit
Reactivity:Wild boar; Pig
Application:Western Blotting; Immunohistochemistry; Immunocytochemistry; Immunoprecipitation
Clonality:Polyclonal
Research area:Enzyme & Kinase; Tumor immunity; Infection immunity
| 20µl | $113.00 | |
| 100µl | $265.00 | |
| 200µl | $378.00 |
| 1ml | $945.00 | |
| 10ml | $3,780.00 |

Antigen:
Matrix Metalloproteinase 2
Synonyms: CLG4; CLG4A; MMP-II; MONA; TBE-1; PEX; Gelatinase A; 72kDa Gelatinase; 72kDa Type IV Collagenase
Host:Mouse
Reactivity:Human
Application:Western Blotting; Immunohistochemistry; Immunocytochemistry; Immunoprecipitation
Isotype:IgG1
Clonality:Monoclonal
Research area:Enzyme & Kinase; Tumor immunity; Infection immunity
| 20µl | $87.00 | |
| 100µl | $203.00 | |
| 200µl | $290.00 |
| 1ml | $725.00 | |
| 10ml | $2,900.00 |

Antigen:
Matrix Metalloproteinase 2
Synonyms: CLG4; CLG4A; MMP-II; MONA; TBE-1; PEX; Gelatinase A; 72kDa Gelatinase; 72kDa Type IV Collagenase
Host:293F
Reactivity:Human
Application:Western Blotting; Immunohistochemistry; Immunocytochemistry; Immunofluorescence
Research area:Enzyme & Kinase; Tumor immunity; Infection immunity
| 20µl | $76.00 | |
| 100µl | $176.00 | |
| 200µl | $252.00 |
| 1ml | $630.00 | |
| 10ml | $2,520.00 |

Antigen:
Matrix Metalloproteinase 2
Synonyms: CLG4; CLG4A; MMP-II; MONA; TBE-1; PEX; Gelatinase A; 72kDa Gelatinase; 72kDa Type IV Collagenase
Host:CHO
Reactivity:Human
Application:Western Blotting; Immunohistochemistry; Immunocytochemistry
Research area:Enzyme & Kinase; Tumor immunity; Infection immunity
| 20µl | $69.00 | |
| 100µl | $161.00 | |
| 200µl | $230.00 |
| 1ml | $575.00 | |
| 10ml | $2,300.00 |

Antigen:
Matrix Metalloproteinase 2
Synonyms: CLG4; CLG4A; MMP-II; MONA; TBE-1; PEX; Gelatinase A; 72kDa Gelatinase; 72kDa Type IV Collagenase
Host:Rabbit
Reactivity:Human
Application:Western Blotting; Immunohistochemistry; Immunocytochemistry; Immunoprecipitation
Clonality:Polyclonal
Research area:Enzyme & Kinase; Tumor immunity; Infection immunity
| 20µl | $63.00 | |
| 100µl | $147.00 | |
| 200µl | $210.00 |
| 1ml | $525.00 | |
| 10ml | $2,100.00 |

Antigen:
Matrix Metalloproteinase 2
Synonyms: CLG4; CLG4A; MMP-II; MONA; TBE-1; PEX; Gelatinase A; 72kDa Gelatinase; 72kDa Type IV Collagenase
Host:Rabbit
Reactivity:Human
Application:Western Blotting; Immunohistochemistry; Immunocytochemistry; Immunoprecipitation
Clonality:Polyclonal
Research area:Enzyme & Kinase; Tumor immunity; Infection immunity
| 20µl | $63.00 | |
| 100µl | $147.00 | |
| 200µl | $210.00 |
| 1ml | $525.00 | |
| 10ml | $2,100.00 |













-SCA100Hu-000001.png)



-APA100Hu02-000001.png)



-SEA100Ra-000001.png)



-E90100Rb-000001.png)



-SEA100Mu-000001.png)

-RPA100Mu01-000001.png)


-RPA100Hu02-000001.png)


-RPA100Hu01-000001.png)





-SEA100Hu-000001.png)

-PAA100Po01-000001.png)









-PAA100Hu01-000001.png)

-PAA100Hu02-000001.png)